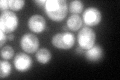
YMR308C
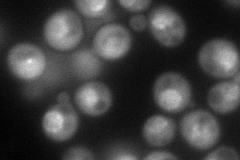
YMR308C
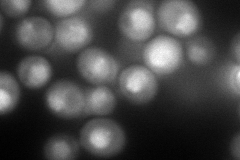
YMR308C
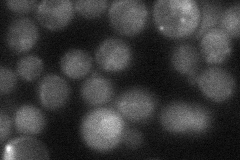
YMR308C
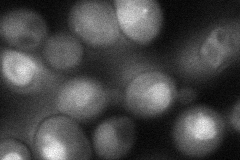
YMR308C
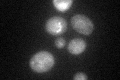
YMR308C

View description
Karyopherin/importin that interacts with the nuclear pore complex; acts as the nuclear import receptor for specific proteins, including Pdr1p, Yap1p, Ste12p, and Aft1p
Localization:
Intensity:
Fold change:
Significance:
-
C’ GFP library in SD
nucleus:cytosol96.15 -
N' NOP1pr-GFP in SD
cytosol,punctate,vacuole membrane147.202 -
N' TEF2pr-mCherry in SD
nucleus144.582 -
N' NATIVEpr-GFP in SD
ambiguous33.5053 -
N' TEF2pr-VC and Cyto-VN in SD
nucleus54.2226 -
C’ GFP library in SD+DTT

technical problem0N/ANo -
C’ GFP library in SD+H2O2

punctateN/AN/ANo -
C’ GFP library in Starvation Media
punctateN/AN/AYes -
C’ GFP library on the background of Pup2-DaMP

nucleus:cytosol -
C’ GFP library on the background of CCT mutant

nucleus:cytosol87.04660.905275No
